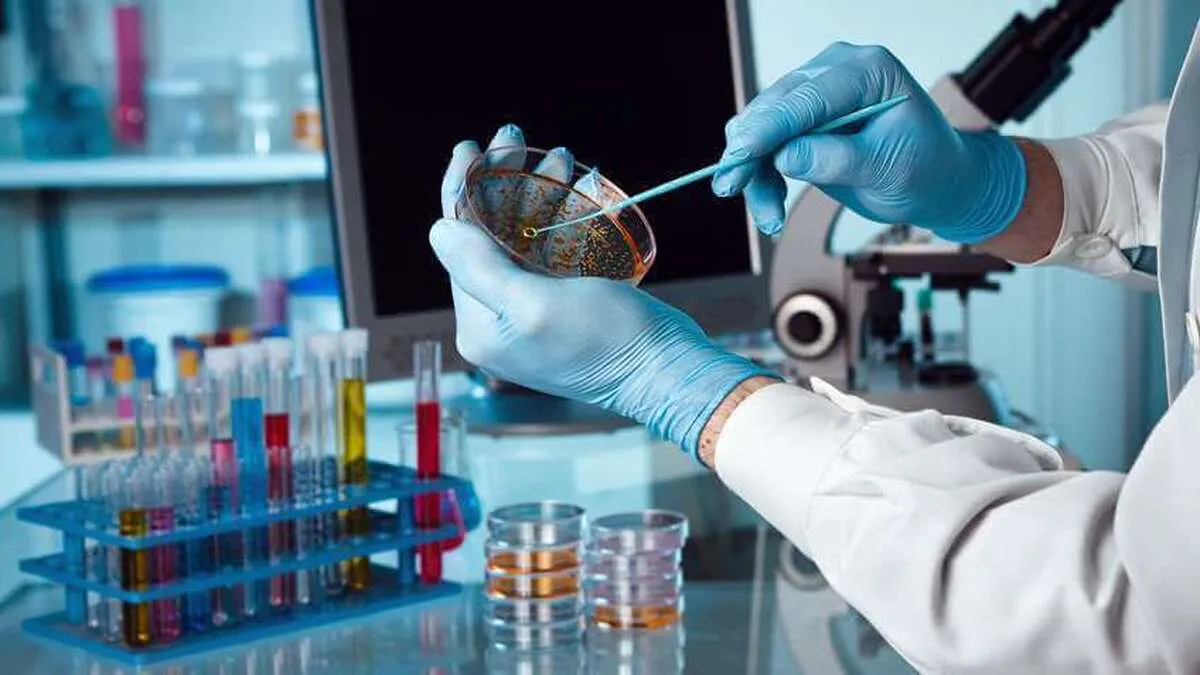

صنعت آزمایشگاهی کشور درگیر بلاتکلیفی/ چه کسانی پاسخگو هستند؟
به گزارش گروه سلامت خبرگزاری آنا،زهرا اردشیری: روز گذشته مصاحبههایی از چند آزمایشگاه معتبر دولتی و خصوصی کشور در خبرگزاری آنا و برخی از رسانهها، خبرگزاریها و پایگاههای خبری منتشر شد که نگرانی در حوزه سلامت را چند برابر و سوالات بسیاری را در ذهن ایجاد کرد. از جمله اینکه:
وقتی قیمت کیت تشخیصی در بازار آزاد ۶ یا ۷ برابرقیمت آن در زمانی است که از تامین کننده رسمی و مجاز تهیه میشود و آزمایشگاه به دلیل عدم تامین توسط شرکتهای تامین کننده آن هم به دلیل نبود ارز ترجیحی، مجبور به خرید آن از بازار آزاد است، چه اصراری به اختصاص ارز ۴۲۰۰ تومانی آنهم به شکل قطره چکانی وجود دارد؟
چه کسی یا کسانی از اینکه آزمایشگاهها مجبور به خرید کیت با ۷ برابر قیمت آن باشند، سود میبرند؟
چرا اداره تجهیزات و ملزومات پزشکی و آزمایشگاهی که متولی و مسئول این امر است و ورود به آن به غیر از برای افرادی خاص آن هم در روزهای خاص و با هماهنگی قبلی! ممنوع است، این کمبود را انکار میکند؟
چرا باید تامین کنندگان با کلی طلب از اداره تجهیزات و ملزومات پزشکی، هر روز با محدودیتها و قوانین خلق الساعه روبه رو شوند تا هرچه بیشتر تامین بازار برای آنها به تاخیر بیفتد و مشکل شود، اما کیتهای قاچاق از ترکیه و عراق با کیفیت نامعلوم دربازار فراوان باشد؟
چرا باید دستگاههای اتوماتیک و پیشرفته گران قیمتی که آزمایشگاههای معتبر به دلیل تنوع ارائه تستهای تشخیصی و کیفیت و دقت بالا، آنها را تهیه کرده اند به دلیل نداشتن کیتهای خاصی که استفاده میکنند، خاموش شوند تا برخی شرکتها محصولات بی کیفیت و با درصد خطای بالای خود را بتوانند در بازار بفروشند؟
ظاهرا این وسط تنها چیزی که ارزش ندارد جان و مال و سلامتی مردم است.
چرا در وزارت بهداشت و درمان و سازمانها و ادارههای وابسته به آن و حتی رئیس کمیسیون بهداشت مجلس شورای اسلامی از کمبود کیتهای آزمایشگاهی و مسائل و مشکلات آزمایشگاهها اظهار بی اطلاعی میکنند؟
چه سیاست و یا منافعی پشت پرده حذف تامین کنندگان کیتهای دستگاههای پیشرفته و گسترش قاچاق این کیتها وجود دارد و سود آنها به جیب چه کسانی میرود که مانع نیمایی شدن ارز واردات آنها میشوند؟
اداره تجهیزات و ملزومات پزشکی و آزمایشگاهی چرا پاسخگوی این سوالات نیست؟ چرا جلوی واردات مواد اولیهی تهیه و تولید کیتها و یا واردات کیتهای دستگاههای پیشرفته را گرفته است؟
آیا اینگونه قرار است طبق فرموده و خواست مقام معظم رهبری، کسی که بیمار است به غیر از رنج و درد بیماری هیچ غم و سختی را تحمل نکند؟ یا اینکه به دلیل سودجویی برخی باندهای مافیایی و نفوذ آنها به بدنهی سازمانهای تصمیم گیرنده، رنجی چند برابر را متحمل شوند؟
جالبتر آنکه رئیس کمیسیون بهداشت مجلس شورای اسلامی که خود باید مطالبه گر حق مردم باشد از کمبودها اظهار بی اطلاعی میکنند.
به نظر میرسد اگر وزارت بهداشت و کمیسیون بهداشت مجلس شورای اسلامی و نهادهای نظارتی دیگر به این موضوع ورود نکنند وضع به مراتب بدتر از این خواهد شد.
انتهای پیام/
انتهای پیام/
- تور استانبول
- غذای سازمانی
- خرید کارت پستال
- لوازم یدکی تویوتا قطعات تویوتا
- مشاوره حقوقی
- تبلیغات در گوگل
- بهترین کارگزاری بورس
- ثبت نام آمارکتس
- سایت رسمی خرید فالوور اینستاگرام همراه با تحویل سریع
- یخچال فریزر اسنوا
- گاوصندوق خانگی
- تاریخچه پلاک بیمه دات کام
- ملودی 98
- خرید سرور اختصاصی ایران
- بلیط قطار مشهد
- رزرو بلیط هواپیما
- ال بانک
- آهنگ جدید
- بهترین جراح بینی ترمیمی در تهران
- اهنگ جدید
- خرید قهوه
- اخبار بورس

























